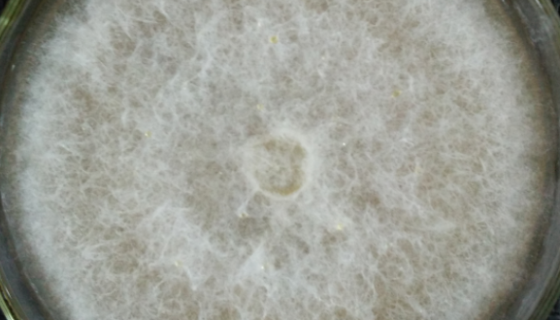
盘长孢状刺盘孢的特征与价值及其培养方法！

拟杆菌属的类别与分类及生物学性状与致病性!
拟杆菌属(Bacteroides)是指革兰氏染色阴性、无芽孢...
盘长孢状刺盘孢的特征与价值及其培养方法!
盘长孢状刺盘孢,一种盘菌(属真菌的一种)。盘长孢状刺盘孢菌是...

Beta-TC-6(小鼠胰岛素瘤胰岛β细胞)的应用!
Beta-TC-6(小鼠胰岛素瘤胰岛β细胞)来源于转基因小鼠...

单核增生李斯特菌的流行病学与风险控制措施!
单核增生李斯特菌(单核增生李斯特菌)一般指单核细胞增生李斯特...

大鼠肺泡上皮细胞系的培养方式与质量检测!
大鼠肺泡上皮细胞系的培养方式与质量检测及注意事项有哪些?

甲基营养型芽胞杆菌——生产耐温淀粉酶
甲基营养型芽胞杆菌是Bacillus属的微生物,原产地为中国...

马拉色菌病的发病原因与临床表现及防治方法!
马拉色菌病(infection of Pityrosporu...

螺卷毛壳——用于生产毛壳菌素和防治镰刀菌
螺卷毛壳是Chaetomium属的微生物,原产地为中国。主要...

研究发现肠道微生物组可能是调节体温的一个因素!
最近的一项研究指出,肠道微生物组可能是调节体温的一个因素,无...